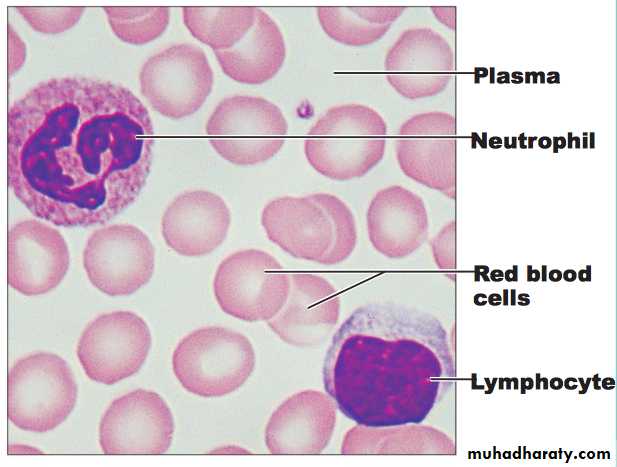

Histology
Histology: is that branch of anatomy that studies tissues of animals and plants. Histology deals with the structure and function of the body.There are 4 level of organization in vertebrate body:
Cell
tissues
system
organism body.
The Cell:
The cell is the basic structural, functional and biological unit of all known living organisms.The types of cells according the shape
1. Spherical shape: eg. white blood cell (W.B.C.)2. Disk shape: eg. red blood cell(R.B.C.)with two concave surfaces.